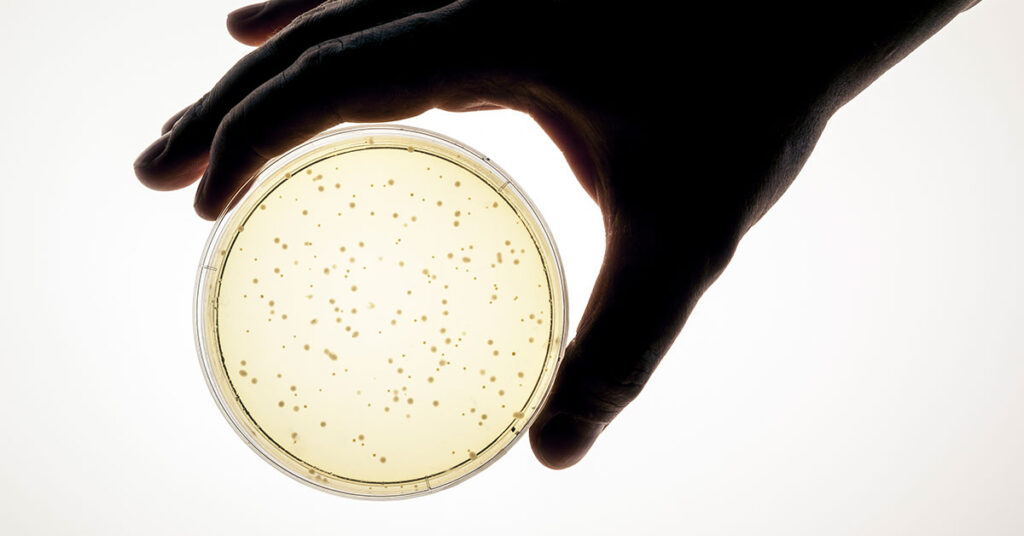
Validation services microbial testing: petri dish with bacterial colonies

Since 1976, Allometrics has delivered precision validation services that ensure your controlled environments meet the strictest regulatory standards across pharmaceutical, biotechnology, healthcare, and manufacturing sectors. Our A2LA-accredited ISO 17025 laboratory, experienced technicians, and nationwide service capabilities provide the technical rigor and documented traceability quality assurance managers need to pass audits—every time.
Comprehensive Validation Solutions Designed for Audit-Ready Compliance
Beyond our accredited calibration capabilities, Allometrics offers integrated validation services that address every aspect of your controlled environment needs:
- Complete Environmental Control Validation – Temperature, humidity, pressure, and airflow testing with detailed documentation that satisfies FDA, cGMP, and other requirements
- Microbial and Particulate Testing – Comprehensive contamination control verification for cleanrooms, compounding pharmacies, and sterile manufacturing facilities
- Preventive Maintenance Programs – Scheduled validation services that prevent costly downtime and maintain continuous compliance between audits
- Emergency Response Capabilities – Rapid validation support when equipment changes or audit findings require immediate corrective action
- Multi-Site Service Coordination – Consistent validation protocols and centralized reporting across all your facilities nationwide
Specialized Validation Services for Every Controlled Environment Application
Temperature Mapping Services
Strategic sensor placement reveals the thermal realities auditors demand to see. Your single-point monitor shows 4°C, but the back corner of your walk-in cooler cycles between 2°C and 7°C—and you won’t know until a failed audit exposes it. Allometrics deploys 9-15 calibrated dataloggers throughout warehouses, freezers, stability chambers, and cleanrooms, delivering spatial and temporal analysis that proves equipment maintains specified ranges during all operational conditions. [1] Get details on our temperature mapping services →
Temperature, Humidity, and Pressure Mapping
When regulatory compliance demands proof that temperature, humidity, AND differential pressure remain stable across operating cycles, single-parameter monitoring leaves dangerous gaps. Our integrated mapping service records all three environmental factors simultaneously during equipment cycles, seasonal variations, and other conditions—preventing product losses. Explore our temperature, humidity, and pressure mapping service →

Microbial Testing
We’re one of the few laboratories in the nation holding A2LA accreditation specifically for environmental monitoring—giving you microbial test results that regulators can’t question. Our comprehensive testing identifies specific organisms (Staphylococcus, Pseudomonas, Aspergillus, and more) with color-coded reports that make contamination risks immediately visible and complete chain-of-custody documentation from collection to analysis. Learn more about our microbial testing capabilities →
Anemometer Calibration Certification
The certificate matters as much as the calibration itself when auditors demand proof of measurement traceability. We provide comprehensive documentation showing complete instrument identification, detailed multi-point calibration results, and clear NIST traceability statements—with options for standard NIST-traceable certificates for internal quality control or ISO 17025 accredited documentation when regulatory compliance specifically mandates accredited calibration, giving you exactly the evidence your audit situation requires. Read more on anemometer calibration certification →
Anemometer Calibration Services
Your cleanroom passed inspection last year, but can you prove your airflow measurements are still accurate today? Anemometer calibration isn’t just about checking a compliance box—it’s about having legally defensible data when auditors question your environmental controls. Our accredited laboratory provides the traceable calibration and documentation that transforms your instruments into audit-ready measurement tools. Explore more about anemometer calibration →
Air Sampler Calibration
Particle counters and viable air samplers measure contamination by pulling precise air volumes through collection media—but when flow rates drift, every count becomes suspect. Our air sampler calibration services verify accuracy to your specifications, preventing the sampling errors that invalidate cleanroom classifications, compromise sterility assurance, and force expensive re-qualification when caught during regulatory inspections or internal audits. Discover more about our air sampler calibration services →

Air Flow & Velocities Calibration
Beyond anemometers and air samplers, our ISO 17025 accredited laboratory calibrates the full range of airflow measurement instruments—manometers, velometers, capture hoods, and aerosol generators—eliminating the vendor management headache of coordinating multiple calibration providers for your environmental monitoring program. Operating from our climate-controlled facility, we’ve specialized in medical, environmental, pharmaceutical, and automotive airflow applications since 1976, with reference standards that maintain accuracy regardless of instrument type. Read on about air flow and velocities calibration services →
Don’t Risk Audit Failures or Costly Downtime. Allometrics’ ISO 17025 accredited validation services provide the documented proof of compliance your facility needs. Call (281) 474-3329 now to schedule validation services or get immediate answers from our technical experts about your specific controlled environment challenges.
Validation Services FAQ: Your Questions About Environmental Compliance Testing Answered
We provide integrated validation services that address every aspect of your controlled environment needs, from environmental control validation to microbial testing. Our ISO 17025 accredited laboratory deploys calibrated instruments throughout your facility to verify equipment maintains specified ranges during operational conditions, delivering detailed documentation that satisfies regulatory requirements.
We offer several validation categories including complete environmental control validation (temperature, humidity, pressure, airflow), microbial and particulate testing, temperature mapping, integrated temperature-humidity-pressure mapping, and air flow measurement instrument calibration. Each category addresses specific compliance requirements for pharmaceutical, biotechnology, healthcare, and manufacturing facilities.
Validation provides documented proof that your controlled environments meet FDA, cGMP, and other regulatory standards auditors demand and necessary trending data. [2] Without validation, equipment drift goes undetected—like walk-in coolers that cycle outside safe ranges—leading to failed audits, product losses, and expensive re-qualification when sampling errors invalidate cleanroom classifications or compromise sterility assurance.
Resources
- https://www.cleanroomtechnology.com/the-critical-role-of-temperature-monitoring-in-the-pharma-cold-chain-208225
- https://ispe.org/india-affiliate/events/how-trend-analyze-environmental-monitoring-data
